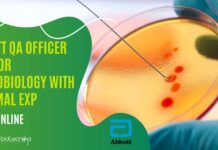
Abbott QA Officer Job For Microbiology With Minimal Exp – Apply Online Abbott QA Officer Vacancy

Home 2024
Yearly Archives: 2024
PGIMER Genetics & Biotechnology Research Associate Recruitment – Applications Invited
PGIMER Genetics Research Vacancy Recruitment - Biotech Apply Now
Department of Anatomy
Postgraduate Institute of Medical Education and Research
Chandigarh
Notice
Applications are invited for the following post in...
CASE STUDY 2: Steps To Achieve Excellence in Life Sciences Field: The Journey of...
Biotech Case Studies: Achieving Excellence in Life Sciences: The Journey of Aditya Iyer
Welcome to our Biotech Success Stories Case Study Series, specially crafted for...
Novonesis (Formerly Novozymes) Hiring BE, MSc Biotech & Biochem For Research Associate Role
Novonesis Biotech Research Associate Job - Biochemistry Apply Online
TS Research Associate I
Locations: Bangalore
Time Type: Full time
Posted on: Posted 2 Days Ago
Job Requisition ID: JR102288
Are you ready for...
Biotecnika Times Newsletter 05.07.2024 – TIFAC Internship Programme, MSD Intern Data Science, CSIR-IICT, Abbott,...
TIFAC Internship Programme Autumn 2024 Session - Apply Online
Apply for the TIFAC Internship Programme for the Autumn 2024 session. This is a great opportunity...
HCCB Coca-Cola QA Vacancy For MSc Microbiology, Apply Online
HCCB Coca-Cola QA Vacancy For MSc Microbiology, Apply Online
Executive - Quality Assurance (19769)
Supply Chain
Bidadi Plant (11650029)
Job Description
To ensure all the products manufactured and distributed...
IISER Thiruvananthapuram Life Sciences MSc & PhD Research Job – Apply Now
IISER Thiruvananthapuram Life Sciences MSc & PhD Research Job - Apply Now
RECRUITMENT FOR THE POST OF RESEARCH SCIENTIST - II ON EXTERNALLY FUNDED PROJECTS
The...
TIFAC Internship Programme Autumn 2024 Session – Apply Online
TIFAC Internship Programme Autumn 2024 Session - Apply Online
TIFAC INTERNSHIP PROGRAMME
Applications are invited for the Autumn 2024 session
About the Programme
Technology, which has been key...
IP Lead Job For Biotechnology at Clarivate – Apply Online
IP Lead Job For Biotechnology at Clarivate - Apply Online
Service Operations IP Lead
Noida, Uttar Pradesh, India
Karnataka, India
Hyderabad, Telangana, India
category: Intellectual Property
Remote:...
Editorial Advisor at Springer Nature For Life Sciences, Apply Online
Editorial Advisor at Springer Nature For Life Sciences, Apply Online
Editorial Advisor
Springer Nature Logo
Locations: Pune
Time type: Full time
Posted on: Posted Yesterday
Job Requisition ID: JR100079
Springer Nature opens the...
GSK Publications Operations Lead For BTech & MTech Biotech, Apply Online
GSK Publications Operations Lead For BTech & MTech Biotech, Apply Online
Publications Operations Lead
Job description
Site Name: Bengaluru Luxor North Tower
Posted Date: Jul 4 2024
Req ID:...
HaystackAnalytics (Based out of IIT Bombay) NGS Sequencing Specialist Job For Mol Bio, Biotech...
HaystackAnalytics NGS Sequencing Specialist Job For Mol Bio, Biotech & Genomics
NGS Sequencing Specialist
Navi Mumbai, Maharashtra, India
About the job
Based out of IIT Bombay, HaystackAnalytics is...
MSD Intern Data Science – Last Date to Apply!
MSD Intern Data Science - Last Date to Apply!
Intern-Data Science
Location: Pune, Maharashtra, India
Job Type: Full Time
Intern - Data Science
The Internship Program at our company...
Exciting Job Opportunities at CSIR -IICT For Bioinformatics, Life Sciences, Biotech & Biochem –...
CSIR-IICR Bioinformatics Project Jobs - Life Sciences, Biotech & Biochem Attend Walk-In
CSIR – INDIAN INSTITUTE OF CHEMICAL TECHNOLOGY
Council of Scientific & Industrial Research
Hyderabad –...
Abbott QA Officer Job For Microbiology With Minimal Exp – Apply Online
Abbott QA Officer Vacancy For Microbiology With Minimal Exp - Apply Online
OFFICER - QA
LOCATION INDIA - JHAGADIA
CATEGORY QUALITY
OBJECTIVES:
To conduct the Microbiological analysis...
Biotecnika Times Newsletter 04.07.2024 – Freshers Student Trainee & Research Jobs at SRM-DBT, NIPGR,...
SRM-DBT Hiring! Life Sciences Jobs With Up to Rs. 50,000 pm Pay - Freshers Also Eligible
Apply now for life sciences jobs at SRM-DBT with...